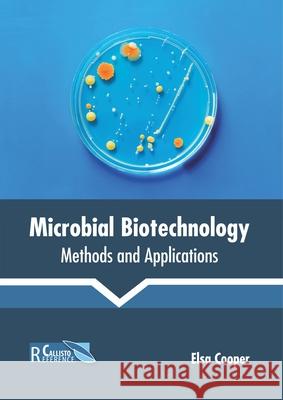
Microbial Biotechnology: Methods and Applications Elsa Cooper 9781641162227 Callisto Reference - książka

Microbial Biotechnology: Methods and Applications » książka
topmenu
Microbial Biotechnology: Methods and Applications
ISBN-13: 9781641162227 / Angielski / Twarda / 2019 / 229 str.
Kategorie:
Kategorie BISAC:
Wydawca:
Callisto Reference
Język:
Angielski
ISBN-13:
9781641162227
Rok wydania:
2019
Dostępne języki:
Ilość stron:
229
Waga:
0.76 kg
Wymiary:
27.64 x 20.32 x 1.42
Oprawa:
Twarda